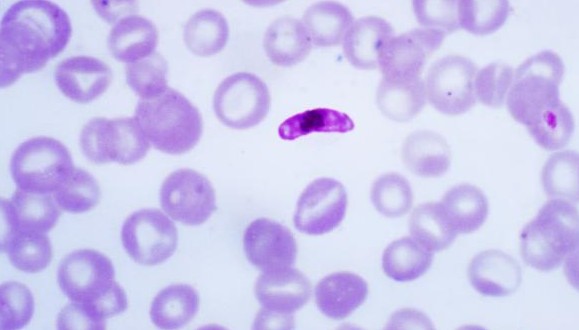

Ecologia de les malalties infeccioses
Les malalties infeccioses i l'ecologia estan molt més a prop del que semblen. Per exemple, tenen un paper fonamental en els ecosistemes, influeixen en les abundàncies de les poblacions salvatges fins al punt, en certs casos, de provocar extincions dels hostes, i molt sovint son factors determinants de la seva evolució. També la transmissió hi està relacionada. Et ve de gust descobrir-ne més?

El meu article anterior pretenia demostrar que no té sentit que ens sorprengui l’aparició d’epidèmies, ja que n’hi ha hagut sempre i les condicions actuals n’augmenten el risc. Vegeu també Ramon Folch. Podeu trobar un llistat d’epidèmies al llarg de la història. Aquí miraré de posar el tema en un context explícitament ecològic.
"La transmissió de les malalties depèn de les característiques del patogen i de les pautes d’agregació, de comportament i organització social dels hostes."
Per començar, les malalties degudes a paràsits patògens sempre han tingut un paper en els ecosistemes. Influeixen en les abundàncies de les poblacions salvatges fins el punt, en certs casos, de provocar extincions dels hostes, i molt sovint com a factors determinants de la seva evolució. La transmissió depèn de les característiques del patogen i de les pautes d’agregació, de comportament i organització social dels hostes. Aquests temes són els que interessen en ecologia. De la taxonomia i els cicles de vida dels paràsits se n’ocupa la parasitologia, mentre que l’estudi dels factors de risc és cosa dels epidemiòlegs (Kilpatrick, i Altizer, 2010).
Un estudi de cas: la pesta bovina de l’Àfrica Oriental
Un exemple clàssic d’estudi ecològic d’una malaltia infecciosa és el de Sinclair i Norton-Griffith (1984). El llibre comença per l’epidèmia de pesta bovina a l’Àfrica Oriental, a finals del s. XIX. La pesta bovina és una malaltia del bestiar domèstic produïda per un morbillivirus proper al del xarampió. Aquella epidèmia esclatà a partir de 1884 amb l’arribada dels ramats russos de l’exèrcit del General Gordon a Kharthoum. Gordon lluitava amb turcs i egipcis contra la rebel·lió de Muhammad Ahmad ibn as Sayyid abd Allah, que es feia dir El Mahdi, i els seus dervixos (El Mahdi és un mític messies àrab descendent del profeta que ha de venir a dirigir la Terra un temps abans de la fi del món). Gordon fou assetjat a Khartoum i decapitat el 1885 (hi ha un film anglès de Basil Dearden, Khartoum, de 1966, amb Charlton Heston com Gordon). El Mahdi va morir sis mesos després, de tifus. Les tropes anglo-egípcies de Lord Kitchener, en les que militava el jove oficial Winston Churchill, reprengueren Khartoum tretze anys després.
La pesta s’expandí el 1890 a l’Àfrica Oriental i sis anys després arribà al Cap.

El 1992, el 95% del bestiar havia mort. Els massai, que en depenien del tot, van patir una fam terrible i la seva població es reduí a un terç de la inicial. Mentre, morien també els búfals, nyus i girafes i molta altra fauna salvatge, inclosos els depredadors que no trobaven preses. Van aparèixer lleons menjadors d’homes, un sol dels qual matà 89 persones (se’n va fer un film amb Michael Douglas, Los demonios de la noche,1991, oblidable). Els agricultors van fugir. Les pastures foren envaïdes per arbusts i arbres i la mosca tsé-tsé, portadora de la tripanosomiasi, trobà molts més hàbitats adients, fet que encara ajudà més a la fugida dels pagesos.

Hi hagué, en les tres dècades següents, diverses onades de la pesta. La recuperació no va començar fins 1925, quan s’observà l’aparició d’animals immunitzats, i el 1930 ja es disposà de maquinària per desbrossar i de vacunes pels ramats. A partir dels anys seixanta i setanta es produí una reconstrucció espontània de les sabanes.
Al 1925 van aparèixer animals immunitzats, cap als anys 60-70 es van reconstruir les sabanes espontàniament i al 2011 es va eradicar la pesta bovina.
La pesta bovina fou del tot eradicada el 2011, essent el segon cas d’una malaltia infecciosa que s’ha pogut eradicar després de la verola. Aquest exemple reflecteix les complexes repercussions ecològiques d’una epidèmia, de la que en foren causa involuntària els exèrcits colonials i que afectaren tot l’ecosistema, inclosos els humans. I l’estudi referit és un exemple d’ecologia de les malalties.
L’ús de models
Hi ha una aproximació més teòrica que la d’aquest llibre, que té precedents notoris en els treballss, primer de Kermack i McKendrick (1927) i, després, d’Anderson i May (1979) o Gets i Pickering (1983) -per cert, l’australià Robert May, que rebé el títol de Baron May of Oxford, un dels noms destacats de l’ecologia del segle XX, format com a físic i autor de treballs destacats en l’ús de models matemàtics i de la teoria del caos en ecologia, va morir als 84 anys aquest 28 d’abril- . Aquesta aproximació empra models que deriven dels models clàssics de relacions depredador-presa introduïts per Volterra i Lotka als anys vint, però no entraré en fórmules (en tot cas, vegeu requadre). En essència, hi ha dues poblacions, la de l’hoste i la del paràsit, com passa en les relacions depredador-presa. Segons Anderson i May (1979) els paràsits poden ser virus, bacteris, protozous, helmints i artròpodes. Tenen com a hàbitat un altre organisme, almenys durant algun estadi del seu cicle de vida, i limiten el creixement de les poblacions de l’hoste, sigui planta o animal perquè n’alteren la mortalitat, com també fan els depredadors o les limitacions ambientals. Poden ser un factor decisiu en poblacions d’alguns mamífers i sembla que de manera més general, en ocells.

Naturalment, la mida del paràsit és important, perquè els molt petits tenen generacions de curta durada, taxes de reproducció molt elevades i, en general, provoquen respostes immunitàries, així que el temps d’infecció és curt comparat amb la durada normal de vida de l’hoste. En canvi, si es tracta d’helmints o artròpodes, molt més grans, viuen més temps, es reprodueixen menys i les infeccions poden perdurar sense que es produeixi immunització. En uns i altres hi ha molts tipus diferents de cicles de vida que de vegades passen per hostes intermediaris, cosa que complica els models que es vulguin fer. A més, la transmissió en la població d’hostes pot ser entre individus (horitzontal) o de pares a fills (vertical). Aquí parlaré només dels microparàsits i no d’helmints i artròpodes.
En els models clàssics anomenats SIR la població de l’hoste està formada per S individus susceptibles (però no infectats), I infectats i R recuperats. El total N = (S+I+R) i cadascun d’aquests grups, a més de les taxes normals de naixement i mortalitat de la població, varien també en funció de l’acció dels paràsits, que depèn de la seva capacitat infectiva, del seu efecte sobre la mortalitat i de la durada de la immunitat en els recuperats. A partir d’aquestes variables, Anderson i May proposen un sistema de tres equacions diferencials per la dinàmica en el temps de les tres subpoblacions S, I i R. El punt important és que la propagació de la infecció depèn del grau de transmissió del paràsit quan entren en contacte individus susceptibles i infectats, que vol dit que les interaccions SI estan afectades per un factor de transmissió: βSI. Aquest factor de transmissió β sol dependre de la taxa de reproducció del paràsit, de la dinàmica del vector que el transmet (p.e. mosquit, gotes de vapor emeses, etc., però de vegades no hi ha vector, p.e. en la transmissió sexual) i de la taxa d’invasió. El paràsit regularà la població d’hostes si la mortalitat que provoca és major que la diferència entre naixements i morts quan no hi ha el paràsit. Si la densitat dels X està per sota d’un cert llindar, les infeccions disminuiran (un motiu pel confinament).
El Número bàsic de reproducció, un indicador de la velocitat de propagació difícil de calcular i emprar
El número bàsic de reproducció R0 és el nombre esperat de casos secundaris produïts per un sol individu infectat en una població completament susceptible. És el producte de la transmissibilitat t (probabilitat d’infecció en cada contacte entre un individu susceptible i un infectat) per la taxa mitjana de contactes entre susceptibles i infectats c (o sigui contactes/temps) per la durada de la infectivitat d (o sigui, temps/infecció). Si les fraccions corresponents a cada categoria són s = S/N, i= I/N, r= R/N, el sistema d’eqüacions donarà els valors de la variació amb el temps de cada fracció, ds/dt, di/dt i dr/dt. Si diem β al producte tc i v a la taxa d’immunització, el sistema serà:
ds/dt = -βsi
di/dt = βsi – v
dr/dt = v
Se suposa que totes les taxes són constants.
L’epidèmia té lloc si βsi – v > 0 i βsi/ v > 1; a l’inici, tots els individus es poden considerar susceptibles, o sigui que s és aproximadament 1 i tindrem R0 = β/v > 1
El valor de R0 és un indicador usat en valorar l’estat d’un procés epidemiològic, però el seu valor canvia amb el temps i entre llocs per una mateixa malaltia i cal ser prudents en l’ús dels valors calculats. Avui es creu que a Espanya el COVID19 té un R0 proper a 5.7, més del doble d’una grip normal o de l’ebola, semblant al de les paperes o la tos ferina, la meitat que la varicela i menys de la meitat que el xarampió. Una vacunació eficaç ha d’arribar a una proporció de 1 – 1/R0 de la població.
Però no sempre hi ha un llindar. Getz i Pickering (1983) van advertir que cada epidèmia és única i que això limita la utilitat dels models teòrics, que s’han d’anar adaptant sobre la marxa. Els models més moderns tenen present que les transmissions tenen lloc en un marc de xarxes de contacte: els hostes es reparteixen de manera irregular en l’espai i cada individu té més probabilitats de contactar amb cert nombre d’altres que amb la resta (en els humans, família, amics, col·legues professionals o usuaris del mateix mitjà de transport a hores semblants). Aquesta aproximació en xarxa es distancia dels vells models de Volterra i Lotka, dels que es deia que feien ballar l’ecosistema en la punta d’una agulla: no tenien en compte l’espai i tots els individus de preses i depredadors tenien igual probabilitat de trobar-se.

Cal tenir sempre clar que no és la malaltia el què es transmet entre els individus hoste, sinó el paràsit.
Ja es pot veure que és molt difícil conèixer les variables i coeficients de les equacions: en el cas de la COVID 19 no sabem bé ni la capacitat infectiva, ni la durada de la immunitat, ni el factor de transmissió, ni el llindar... A més, els models actuals han de tenir present que la susceptibilitat de l’hoste a la infecció no és idèntica en tots els individus. En la pandèmia de COVID19 hem tingut molt clar que, si bé tots els individus es podien infectar (no n’hi havia d’immunitzats prèviament, ni per haver passat la malaltia ni per haver estat vacunats, ja que no tenim vacuna), que es desenvolupés o no la malaltia depenia de l’edat i de l’estat de salut de cada persona. Això val també per altres animals i per plantes davant de l’atac d’una espècie paràsita o patògena. Per tant, els models hauran de dividir la subpoblació S en classes de susceptibilitat. D’altra banda, el risc d’infecció depèn d’altres coses, com l’aïllament, com ja he dit, i cal tenir sempre clar que no és la malaltia el què es transmet entre els individus hoste, sinó el paràsit. En definitiva, els models per l’actual pandèmia no poden ser gaire fiables perquè ens manquen molts coneixements encara.
Dues modalitats d’infecció
"La COVID19 i altres infeccions de transmissió molt directa entre individus s’acosten més a la dependència de la densitat, mentre que les infeccions sexuals com la SIDA i les que impliquen vectors com la Malària estan més a prop de dependre de la freqüència"
De vegades, la transmissió del patogen augmenta amb la densitat de l’hoste. Això es coneix com transmissió depenent de la densitat, o sigui de la població total. Llavors, la transmissió només es produeix per damunt d’un cert llindar de densitat d’hostes, fet important pel control. Però d’altres cops la densitat d’hostes no afecta gaire a la transmissió, la qual depèn de la freqüència, és a dir de la proporció entre infectats i població total (I/(S+I+R). En aquesta alternativa, no hi ha un llindar de població sinó que la infecció pot persistir amb densitats molt baixes dels hostes. Aquests dos casos es poden considerar els extrems de tota una varietat de situacions que es troben en la realitat. La COVID19 i altres infeccions de transmissió molt directa entre individus s’acosten més a la dependència de la densitat, mentre que les infeccions sexuals com la SIDA i les que impliquen vectors com la malària (els mosquits) estan més a prop de dependre de la freqüència.

Si hi ha dependència de la densitat, els patògens poden arribar a regular les poblacions d’hostes en determinats casos (Kilpatrick i Altizer, 2010), però és rar que causin la seva extinció. Hi ha, però, l’efecte anomenat Allee, que diu que la probabilitat d’extinció és major quan les poblacions són petites (en una població petita dispersa és difícil trobar parella per reproduir-se), i si una infecció redueix molt la població d’una espècie i això es combina amb l’efecte Allee es pot arribar a l’extinció (Hilker, 2010): en funció de com són les relacions socials i el comportament dels hostes, l’efecte Allee pot ser fort (els ossos polars podrien ser un exemple, Mólnard et al. 2008), i una epidèmia pot desencadenar efectes catastròfics sobtats. A més, les infeccions tenen més efecte si l’estat nutricional de l’hoste és dolent (com ara els passa als ossos polars).

Una manera de lluitar contra la infecció depenent de la densitat és el sacrifici d’individus. En el meu primer Apunt vaig parlar de la plaga de les oliveres a Itàlia: el que es feia era talar oliveres en un ample front davant del progrés de l’epidèmia. En malalties humanes, s’empra la quarantena per reduir les aglomeracions i els contactes, però en la història també hi ha exemples d’eliminació de persones malaltes (sobretot per evitar que mirin de fugir del seu aïllament). Les vacunes s’han d’aplicar a una proporció suficient de la població i són útils no sols pels vacunats: els individus susceptibles tenen menys probabilitats de ser infectats si estan voltats d’individus vacunats. Se sap que, normalment, una part petita d’individus són causants de la major part d’infeccions, així que convé detectar aquests individus i aïllar-los.
"En infeccions dependents de la freqüència, si hi ha molts hostes es pot produir un efecte de dilució que esmorteeix l’impacte de l’epidèmia."
La COVID19 sembla, per sort, no infectar els animals domèstics (només se sap d’algun cas amb gats), però en la pesta negra a més dels humans intervenen com a mínim les rates i les puces de les rates. Això complica les coses. L’exemple de la pesta bovina seria un cas en el que hi ha molts hostes. En infeccions dependents de la freqüència, si hi ha molts hostes es pot produir un efecte de dilució que esmorteeix l’impacte de l’epidèmia (Keesing et al. 2006), però alguna espècie concreta pot resultar afectada de manera catastròfica.
Aspectes evolutius
Una pregunta clàssica és per quin motiu els paràsits fan mal i, fins i tot, destrueixen els hostes, quan la seva vida depèn d’aquests hostes (Anderson & May 1982, Read 1994). D’una banda, com que els patògens entren en els teixits de l’hoste i es nodreixen d’ells o dels seus recursos per mantenir-se o reproduir-se, algun dany és inevitable. Segons una teoria, només confirmada en alguns casos, la selecció natural descarta els paràsits extremadament virulents que es reprodueixen tan ràpid que maten l’hoste abans de trobar-ne un altre; igualment, els que es reprodueixen massa lentament tenen problemes per ser transmesos a temps. Cal, per tant, que els paràsits tinguin unes taxes de reproducció intermèdies que donin temps a la transmissió abans de la mort de l’hoste. La qüestió de la virulència és important. Si la malaltia és molt virulenta, els hostes moren molt ràpid i la transmissió s’interromp aviat. Són els patògens de virulència mitjana els que tenen més efectes a llarg termini sobre les poblacions d’hostes i sobre el conjunt dels ecosistemes.

També els hostes estan subjectes a evolució en front dels paràsits. Hi ha dues estratègies possibles, la de tolerància i la de resistència. En la primera, l’hoste tendeix a reduir els danys però deixa que el paràsit es reprodueixi i es transmeti. En la de resistència, l’hoste pot desenvolupar mecanismes per reduir la probabilitat de ser infectat, o la de que el paràsit es reprodueixi dins seu, o per recuperar-se eliminant ràpidament el paràsit. Sembla que l’estratègia de resistència hauria de prevaldre, però l’hoste ha de trobar un compromís entre diverses necessitats i els paràsits poden evolucionar en contra de les adaptacions de resistència de l’hoste, així que no hi ha respostes senzilles. El que tenim és un procés co-evolutiu segons un model de Tom i Jerry: A cada invent de l’hoste succeeix un del paràsit i viceversa. El resultat serà, finalment, l’existència de molts genotips d’hostes i de paràsits i només algunes combinacions hoste-paràsit donaran lloc a infecció. No cal dir que els canvis ambientals poden alterar aquesta relació.
Malalties infeccioses i ecosistemes
Hem vist en la introducció que una malaltia infecciosa pot alterar molt tot un ecosistema. Alhora, l’emergència de malalties pot dependre de les alteracions de l’ecosistema. En el cas de la pesta bovina, l’alteració de l’hàbitat que provocava afavoria l’expansió d’una altra malaltia, la tripanosomiasi... i també la de situacions de fam que afectaven la mortalitat d’algues espècies, inclosos els humans. Per aquest tema dels processos ecosistèmics en relació a la salut, recomano la consulta del capítol 14 del Millenium Assessment (Amerasinghe et al. 2004) i el document de la Wildlife Conservation Society (WCS) en pdf, d’abril d’aquest any.
Una malaltia infecciosa pot alterar molt tot un ecosistema. Alhora, l’emergència de malalties pot dependre de les alteracions de l’ecosistema.
En el primer hi trobareu exemples d’associacions entre transformacions del medi per l’activitat humana, malalties infeccioses i augment de la resistència als antibiòtics. S’hi assenyala que les zones de frontera amb ecosistemes naturals i zones urbanes o agrícoles són sovint propícies a la transferència de patògens i vectors. Quan la frontera és de zones urbanes amb boscos tropicals trobem malària, febre groga i dengue, i febres hemorràgiques en els límits entre boscos tropicals i zones agrícoles. El kala-azar o la pesta són més propis de zones seques, la leishmaniosi cutània ho és de zones forestals. Les malalties prioritàries són la malària en molts ecosistemes, l’esquistosomiasi, la filariasi limfàtica i l’encefalitis del Japó en zones tropicals cultivades i d’aiguamolls interiors, el dengue en ciutats, la leishmaniasi i la malaltia de Chagas en zones forestals i terres àrides, la meningitis al Sahel, el còlera en sistemes litorals, aigües dolces i sistemes urbans i el virus del Nil occidental i la malaltia de Lyme en sistemes urbans i suburbans d’Europa i Nord-Amèrica.
L’alteració d’hàbitats canvia el nombre de llocs de cria dels vectors o la distribució dels hostes que són reservori de patògens, les transferències a altres hostes, les pèrdues de depredadors i canvis en les poblacions d’hostes, l’increment de resistència i la contaminació.
El risc d’alterar la incidència d’aquestes malalties, ens diu aquest informe que ja té 14 anys, augmenta amb la destrucció i invasió d’hàbitats salvatges per tales i construcció de carreteres, canvis en la disponibilitat i distribució d’aigües superficials i construcció d’embassaments, regadius o desviació de rius, augment de l’ús ramader o agrícola, deposició de contaminants químics (adobs, plaguicides), disseminació urbana, alteració del clima, migracions i augment de desplaçaments i del comerç internacionals i introduccions accidentals o no de patògens pels humans. Els projectes de desenvolupament poden reduir el risc d’infeccions amb mesures de gestió i protecció. Cal tenir en compte que l’alteració d’hàbitats canvia el nombre de llocs de cria dels vectors o la distribució dels hostes que són reservori de patògens, les transferències a altres hostes, les pèrdues de depredadors i canvis en les poblacions d’hostes, l’increment de resistència (observada en mosquits als plaguicides i en bacteris als antibiòtics) i la contaminació. Els embassaments i recs són hàbitats per a cargols, hostes intermediaris de l’esquistosomiasi; els arrossars augmenten les àrees de cria dels mosquits que transmeten malària, filariasi limfàtica, encefalitis del Japó i febre del Rift-Valley; la desforestació augmenta el risc de malària a l’Àfrica i Sud-Amèrica. No és menys cert que la destrucció de certs hàbitats favorables als mosquits elimina riscos. Tot això se sap, dons, de fa temps, però ara a la majoria, no sols de la gent sinó dels gestors públics, els ve de nou.

Segons l’OMS, les malalties infeccioses suposen una quarta part del total de malalties (a l’Àfrica, prop del 50 % de la població en pateix) i algunes de les abans esmentades estan en expansió, alhora que n’apareixen de noves. Sabem que algunes, com la tuberculosi, el xarampió i la verola, són zoonosis, ens van venir de la domesticació de bestiar. Molts patògens que es propaguen de persona a persona procedeixen de zoonosis però han evolucionat en la relació amb nosaltres i alguns virus fins i tot s’han incorporat al nostre genoma i han esdevingut malalties genètiques. Els molt ràpids canvis ambientals, demogràfics i de transport dels dos segles darrers han contribuït a l’emergència de nous patògens i, de les malalties infeccioses humanes, només la verola ha estat eradicada. Les malalties causades per patògens que viuen part del temps en medis externs a les persones, com l’aigua o organismes vectors són les que més han estat influïdes pels canvis ambientals. Però la lluita contra les malalties infeccioses demana un gran coneixement de la biologia dels patògens, dels vectors i dels hostes, així com de les condicions del medi. Segons Carroll et al. (2018), els virus que sabem que infecten humans són menys de 300, però hi ha estimacions que diuen que, en les mateixes 25 famílies víriques de risc, en ocells i mamífers, hi podrien haver de l’ordre de 700.000 virus potencialment zoonòtics d’un total de 1.7 milions.

Es consideren malalties emergents les que han incrementat la seva incidència o l’àrea de distribució (com la malaltia de Lyme, la tuberculosi, els virus del Nil Occidental i Nipah), que han evolucionat (noves variants de grip, SARS o formes de malària resistent als medicaments), o que s’han descobert (virus de Hendra o de l’ebola, COVID19), etc. El Millenium ens explica que, massa sovint, les grans inversions en embassaments i regadius han tingut pros i contres en termes de cost-benefici, i una part significativa dels contres es relaciona amb l’expansió de malalties infeccioses. Això només es un exemple de com s’alteren aspectes de salut amb les transformacions ambientals i l’augment del transport horitzontal de persones i coses, perquè s’alteren cicles de vida, probabilitats de contagi, llocs de cria, invasions biològiques, taxes evolutives , etc.
Massa sovint, les grans inversions en embassaments i regadius han tingut pros i contres en termes de cost-benefici, i una part significativa dels contres es relaciona amb l’expansió de malalties infeccioses.
Hi ha més de 1400 espècies patògenes pels humans. D’elles, el 61% són zoonòtiques. De les malalties infeccioses emergents, el 75% ho són. Es tracta sovint de virus que passen d’un animal als humans i evolucionen en noves formes. Per aquest motiu, no tenim eines per lluitar-hi, com vacunes o fàrmacs, i per això són tan perillosos: és el cas de la SIDA, l’ebola, la malaltia del Nipah, l’hantavirus, nous virus de la grip... entre ells els que venen d’ocells, com el H5N1, que va originar molta preocupació i va provocar que l’OMS fes una campanya per la vacunació massiva contra el H1N1 de la grip de 2009-10 que només causà al final 12.000 morts i que, lamentablement, va estimular els moviments anti-vacunes, que van considerar que l’alarma només era un intent de fer diners de certes empreses farmacèutiques. Una grip aviar, H7N9, es detectà el 2013 a la Xina i havia infectat algunes persones en contacte amb ocells. Se sap que calen molt poques mutacions per el pas d’aquests virus de les aus als mamífers. En el cas de les vaques boges, la malaltia, que es transmet als humans, la causa una proteïna rara, coneguda com prió, i es desencadena en augmentar les proteïnes en l’aliment de les vaques amb residus de cervells i medul·les de vaques i ovins, quan tothom sap que les vaques són herbívores i quan en ovelles i humans es coneixien malalties similars (el kuru en caníbals de Nova Guinea, que és la malaltia de Creutzfeldt-Jakob). El SARS és un virus aparegut en els mercats d’animals vius xinesos (mercats humits), coneguts com a font de virus de la grip des dels anys 1970 amb hostes intermediaris en rat-penats, civetes de palmera (Paguna larvata), mapatxes asiàtics (Nyctereutes procuyoinboides) i teixons xinesos (Melogale moschata). És un precedent clar del virus COViD 19, com també ho és el MERS.

Sobre el risc d’epidèmies en una població humana creixent, vegeu Gholipour (2013). Els càlculs demogràfics pronostiquen que la població humana arribarà a 9600 milions el 2050 i a 11000 milions el 2100. L’ecòleg Peter Daszak (explicant un treball del seu equip, Jones et al. 2008) ja va dir que hi havia una forta correlació entre el risc de pandèmies i la densitat de la població humana i que el nombre de malalties infeccioses emergents havia augmentat significativament (de l’ordre de 300 noves entre 1940 i 2004, unes per zoonosi i d’altres per aparició de varietats resistents als tractaments), tot i la millora de les tècniques de diagnosi i vigilància. Van veure que totes les noves malalties s’associaven a creixement sobtat de la població humana, noves activitats en el medi i presència de força diversitat de fauna salvatge en el lloc d’origen del patogen. Morand et al. (2014) troben que, tot i que la biodiversitat és una font de patògens, on més problemes s’han produït és allà on hi ha més espècies en risc d’extinció i més pèrdua de superfície forestal i creuen que, si està ben preservada, la biodiversitat podria funcionar com una assegurança contra els brots epidèmics, però que manca molta recerca per confirmar els resultats a nivell regional i local per tal que el planejament pugui integrar objectius de gestió de la biodiversitat i de millora de la salut.
Tot i que la biodiversitat és una font de patògens, on més problemes s’han produït és allà on hi ha més espècies en risc d’extinció i més pèrdua de superfície forestal i creuen que, si està ben preservada, la biodiversitat podria funcionar com una assegurança contra els brots epidèmics.
És d’esperar que la crisi econòmica que ja tenim no comporti retallades en sanitat, després de l’experiència, però convindria que tampoc n’hi hagués en recerca biomèdica i ecològica, donat que hi ha tant que encara no sabem sobre aspectes de l’ecologia que condicionen la prevenció i la lluita davant malalties infeccioses emergents.
Demòcrit d’Abdera va dir que la natura es basta a ella mateixa i per això venç amb el menys i el segur els excessos de l’esperança. I Isaac Asimov va aconsellar-nos: si el coneixement pot crear problemes, no és amb la ignorància que els resoldrem.
Referències
F.P. Amerasinghe et al. 2004. Human Health: Ecosystem Regulation of Infectious Diseases. Millenium Assessment. https://www.millenniumassessment.org/documents/document.283.aspx.pdf
Anderson, R.M., R.M. May. 1979. Population biology of infectious diseases: Part !. Nature 280: 361-367.
Carroll et al. 2018. The Global Virome Project. Science. 359: 872–874. doi:10.1126/ science.aap7463
Jones, K.E., N.G. Patel, M.A. Levy, A. Storeygard, D. Balk, J.L. Gittleman, P. Daszak. 2008. Global trends in emerging infectious diseases. Nature 451. doi:10.1038/nature06536
Getz, W., J. Pickering. 1983. Epidemic models- Thresholds and population regulation. The Am. Nat. 121(6):892-898
Gholipour, B. 2013. What 11 billion mean for disease outbreaks, Scientific American, novembre
F.M. Hilker. 2010. Population collapse to extinction: the catastrophic combination of parasitism and Allee effect. Journal of Biol. Dynamics, 4: Workshop on population dynamics and mathematical biology, Luminy, France, june 2008
Kilpatrick, A. M., S. Altizer. 2010. Disease Ecology. Nature Education Knowledge 3(10):55).
Molnár, P.K., A-E_ Derocher, M-A- Lewis, M.K. Taylor. 2008. Modelling the mating System of polar bears: a mechanistic approach to the Allee effect. Proc. Biol. Soc. 275: 217-226,
Morand, S., S. Jittapalapong, Y. Suputtamongkol, M.T. Abdullah, T.B. Huan. 2014. Infectious Diseases and Their Outbreaks in Asia-Pacific: Biodiversity and Its Regulation Loss Matter. PLoS ONE 9(2): e90032. https://doi.org/10.1371/journal.pone.0090032
Read. A. F. 1994. The evolution of virulence. Trends in Microbiol. Pp.73-76-
Sinclair, A.R.E., M. Norton-Griffith. 1984. Serengeti: Dynamics of an ecosystem. The Chicago Univ. Press, Chicago i Londres
